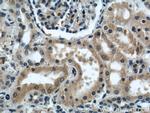
KIF5B Antibody in Immunohistochemistry (Paraffin) (IHC (P))

Search
Proteintech
KIF5B Polyclonal Antibody
{{$productOrderCtrl.translations['antibody.pdp.commerceCard.promotion.promotions']}}
{{$productOrderCtrl.translations['antibody.pdp.commerceCard.promotion.viewpromo']}}
{{$productOrderCtrl.translations['antibody.pdp.commerceCard.promotion.promocode']}}: {{promo.promoCode}} {{promo.promoTitle}} {{promo.promoDescription}}. {{$productOrderCtrl.translations['antibody.pdp.commerceCard.promotion.learnmore']}}

Please note: We are reviewing Western blot images included in the antibody testing data in our catalog, including those provided by third parties. Unless expressly labeled or annotated as “raw-unedited”, Western blot images included in the antibody testing data in our catalog may have been edited, optimized or otherwise adjusted for presentation.
产品信息
21632-1-AP
种属反应
已发表种属
宿主/亚型
分类
类型
抗原
偶联物
形式
浓度
规格
纯化类型
保存液
内含物
保存条件
运输条件
产品详细信息
Immunogen sequence: ESVDALSEE LVQLRAQEKV HEMEKEHLNK VQTANEVKQA VEQQIQSHRE THQKQISSLR DEVEAKAKLI TDLQDQNQKM MLEQERLRVE HEKLKATDQE KSRKLHELTV MQDRREQARQ DL (662-782 aa encoded by BC126279)
靶标信息
Microtubule-dependent motor required for normal distribution of mitochondria and lysosomes. Can induce formation of neurite-like membrane protrusions in non-neuronal cells in a ZFYVE27-dependent manner. Regulates centrosome and nuclear positioning during mitotic entry. During the G2 phase of the cell cycle in a BICD2-dependent manner, antagonizes dynein function and drives the separation of nuclei and centrosomes. Required for anterograde axonal transportation of MAPK8IP3/JIP3 which is essential for MAPK8IP3/JIP3 function in axon elongation.
仅用于科研。不用于诊断过程。未经明确授权不得转售。
生物信息学
蛋白别名: Conventional kinesin heavy chain; kif5b {ECO:0000312|EMBL:ABC25059.1}; kinesin heavy chain member 5B, ubiquitous; Kinesin-1 heavy chain; U-KHC; Ubiquitous kinesin heavy chain; UKHC
基因别名: AL022807; Khc; Khcs; KIF5B; KNS; KNS1; Ukhc
UniProt ID: (Mouse) Q61768, (Rat) Q2PQA9
Entrez Gene ID: (Mouse) 16573, (Rat) 117550




